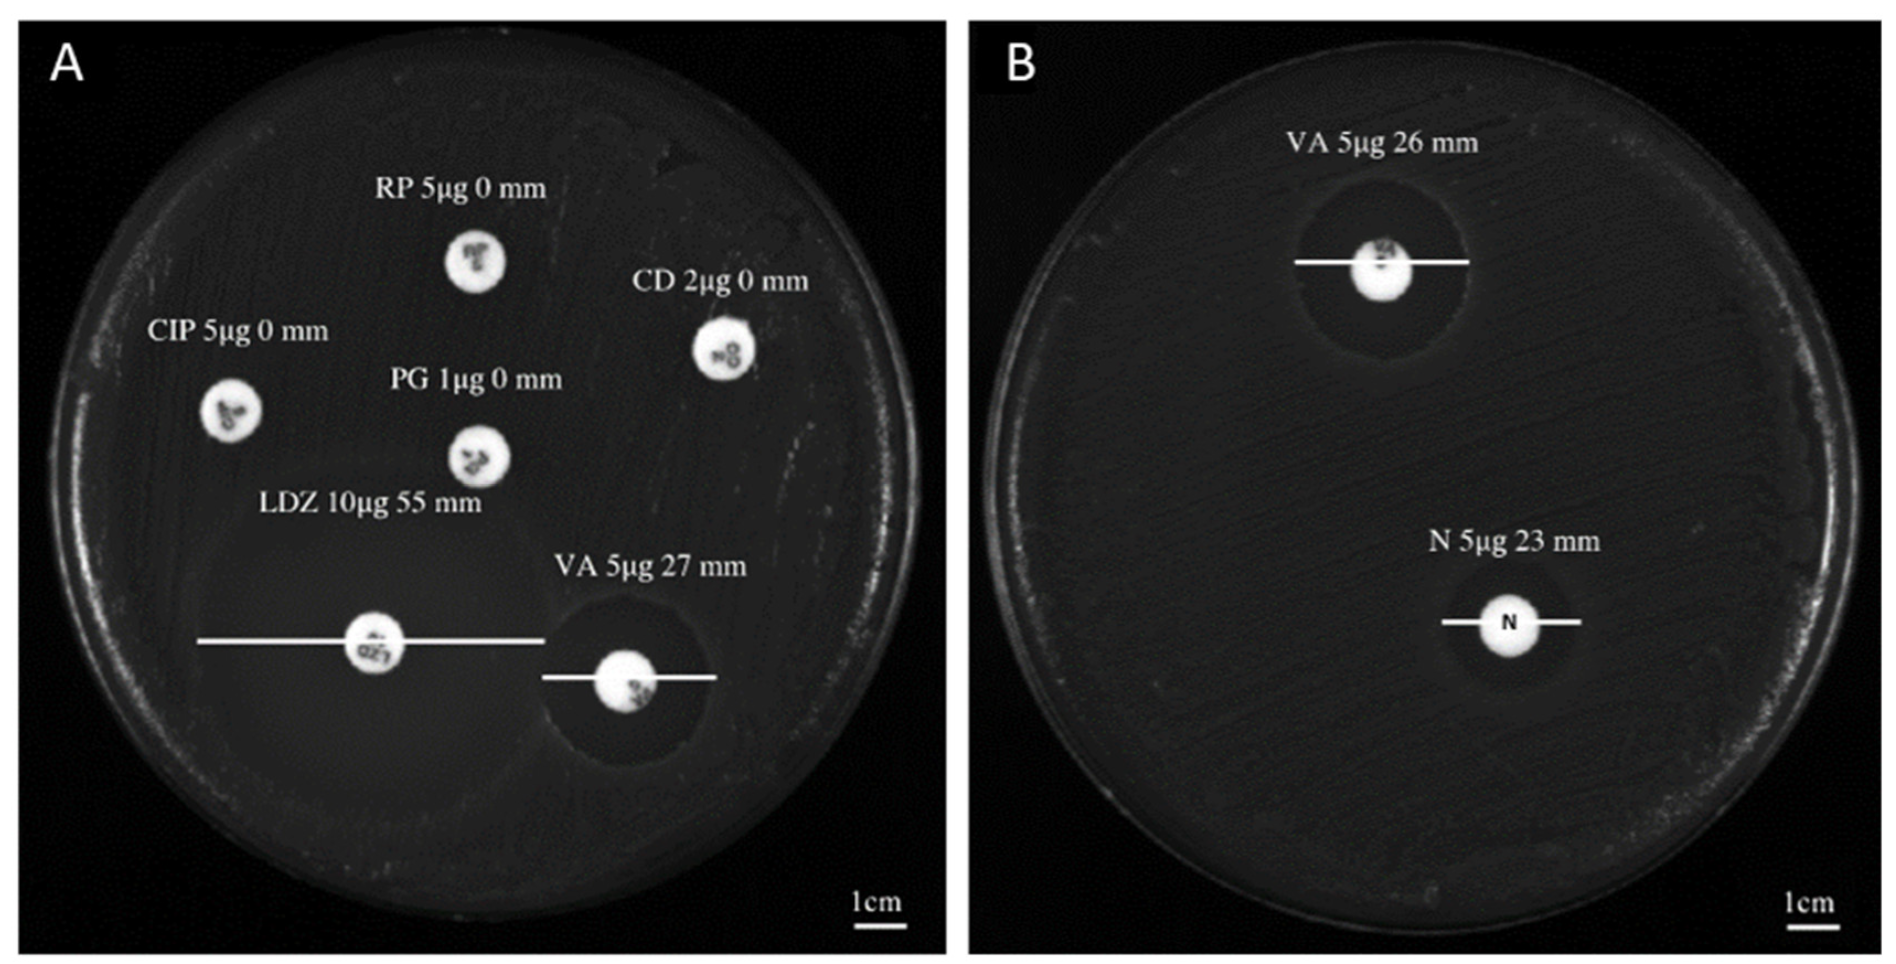
Antibiotics 11 00651 g001

Niclosamide as a Repurposing Drug against Corynebacterium striatum Multidrug-Resistant Infections
Abstract
:1. Introduction
2. Results
2.1. Antibacterial Profile
2.2. Estimation of the Biomass and Viability of Biofilm Cell
2.3. Cytotoxicity of Niclosamide
2.4. Bacterial Invasion and Intracellular Inhibition Assay
3. Discussion
4. Materials and Methods
4.1. Preparation of the Compound
4.2. Collection and Characterization of Bacterial Isolates
4.3. Kirby–Bauer Disk Diffusion Test
4.4. Determination of the Minimum Inhibitory Concentration
4.5. Time Killing Assay
4.6. SEM Analyses
4.7. Biofilm Degradation and Viability
4.8. CLSM Analysis
4.9. Cell Culture and Cytotoxicity Assays
4.10. Intracellular Activity of Niclosamide
4.11. Statistical Analysis
Author Contributions
Funding
Institutional Review Board Statement
Informed Consent Statement
Conflicts of Interest
References
- Mo, Y.; Low, I.; Tambyah, S.K.; Tambyah, P.A. The Socio-Economic Impact of Multidrug-Resistant Nosocomial Infections: A Qualitative Study. J. Hosp. Infect. 2019, 102, 454–460. [Google Scholar] [CrossRef] [PubMed] [Green Version]
- Bernard, K. The Genus Corynebacterium and Other Medically Relevant Coryneform-like Bacteria. J. Clin. Microbiol. 2012, 50, 3152–3158. [Google Scholar] [CrossRef] [PubMed] [Green Version]
- Folliero, V.; Franci, G.; Dell’Annunziata, F.; Giugliano, R.; Foglia, F.; Sperlongano, R.; De Filippis, A.; Finamore, E.; Galdiero, M. Evaluation of Antibiotic Resistance and Biofilm Production among Clinical Strain Isolated from Medical Devices. Int. J. Microbiol. 2021, 2021, 9033278. [Google Scholar] [CrossRef]
- Verroken, A.; Bauraing, C.; Deplano, A.; Bogaerts, P.; Huang, D.; Wauters, G.; Glupczynski, Y. Epidemiological Investigation of a Nosocomial Outbreak of Multidrug-Resistant Corynebacterium striatum at One Belgian University Hospital. Clin. Microbiol. Infect. 2014, 20, 44–50. [Google Scholar] [CrossRef] [PubMed] [Green Version]
- Oliveira, A.; Oliveira, L.C.; Aburjaile, F.; Benevides, L.; Tiwari, S.; Jamal, S.B.; Silva, A.; Figueiredo, H.C.P.; Ghosh, P.; Portela, R.W.; et al. Insight of Genus Corynebacterium: Ascertaining the Role of Pathogenic and Non-Pathogenic Species. Front. Microbiol. 2017, 8, 1937. [Google Scholar] [CrossRef] [PubMed]
- Alibi, S.; Ferjani, A.; Boukadida, J.; Cano, M.E.; Fernández-Martínez, M.; Martínez-Martínez, L.; Navas, J. Occurrence of Corynebacterium striatum as an Emerging Antibiotic-Resistant Nosocomial Pathogen in a Tunisian Hospital. Sci. Rep. 2017, 7, 9704. [Google Scholar] [CrossRef] [PubMed] [Green Version]
- Silva-Santana, G.; Silva, C.M.F.; Olivella, J.G.B.; Silva, I.F.; Fernandes, L.M.O.; Sued-Karam, B.R.; Santos, C.S.; Souza, C.; Mattos-Guaraldi, A.L. Worldwide Survey of Corynebacterium striatum Increasingly Associated with Human Invasive Infections, Nosocomial Outbreak, and Antimicrobial Multidrug-Resistance, 1976–2020. Arch. Microbiol. 2021, 203, 1863–1880. [Google Scholar] [CrossRef]
- Campanile, F.; Carretto, E.; Barbarini, D.; Grigis, A.; Falcone, M.; Goglio, A.; Venditti, M.; Stefani, S. Clonal Multidrug-Resistant Corynebacterium striatum Strains, Italy. Emerg Infect Dis. 2009, 15, 75–78. [Google Scholar] [CrossRef]
- Morgan, D.J.; Rogawski, E.; Thom, K.A.; Johnson, J.K.; Perencevich, E.N.; Shardell, M.; Leekha, S.; Harris, A.D. Transfer of Multidrug-Resistant Bacteria to Healthcare Workers’ Gloves and Gowns after Patient Contact Increases with Environmental Contamination. Crit. Care Med. 2012, 40, 1045–1051. [Google Scholar] [CrossRef] [Green Version]
- Limoli, D.H.; Jones, C.J.; Wozniak, D.J. Bacterial Extracellular Polysaccharides in Biofilm Formation and Function. Microbiol. Spectr. 2015, 3, 3. [Google Scholar] [CrossRef] [Green Version]
- Petrillo, F.; Pignataro, D.; Lavano, M.A.; Santella, B.; Folliero, V.; Zannella, C.; Astarita, C.; Gagliano, C.; Franci, G.; Avitabile, T.; et al. Current Evidence on the Ocular Surface Microbiota and Related Diseases. Microorganisms 2020, 10, 1033. [Google Scholar] [CrossRef] [PubMed]
- De Souza, C.; Faria, Y.V.; Sant’Anna, L.; Viana, V.G.; Seabra, S.H.; De Souza, M.C.; Vieira, V.V.; Júnior, R.H.; Moreira, L.D.O.; De Mattos-Guaraldi, A.L. Biofilm Production by Multiresistant Corynebacterium striatum Associated with Nosocomial Outbreak. Mem. Do Inst. Oswaldo Cruz 2015, 110, 242–248. [Google Scholar] [CrossRef] [PubMed] [Green Version]
- Rangel-Vega, A.; Bernstein, L.R.; Mandujano-Tinoco, E.A.; García-Contreras, S.J.; García-Contreras, R. Drug Repurposing as an Alternative for the Treatment of Recalcitrant Bacterial Infections. Front. Microbiol. 2015, 6, 282. [Google Scholar] [CrossRef] [PubMed] [Green Version]
- Chen, W.; Mook, R.A., Jr.; Premont, R.T.; Wang, J. Niclosamide: Beyond an antihelminthic drug. Cell Signal. 2018, 41, 89–96. [Google Scholar] [CrossRef] [PubMed]
- El-Saber Batiha, G.; Alqahtani, A.; Ilesanmi, O.B.; Saati, A.A.; El-Mleeh, A.; Hetta, H.F.; Magdy Beshbishy, A. Avermectin Derivatives, Pharmacokinetics, Therapeutic and Toxic Dosages, Mechanism of Action, and Their Biological Effects. Pharmaceuticals 2020, 13, 196. [Google Scholar] [CrossRef] [PubMed]
- Rajamuthiah, R.; Fuchs, B.B.; Conery, A.L.; Kim, W.; Jayamani, E.; Kwon, B.; Ausubel, F.M.; Mylonakis, E. Repurposing Salicylanilide Anthelmintic Drugs to Combat Drug Resistant Staphylococcus Aureus. PLoS ONE 2015, 10, e0124595. [Google Scholar] [CrossRef] [Green Version]
- Gwisai, T.; Hollingsworth, N.R.; Cowles, S.; Tharmalingam, N.; Mylonakis, E.; Fuchs, B.B.; Shukla, A. Repurposing Niclosamide as a Versatile Antimicrobial Surface Coating against Device-Associated, Hospital-Acquired Bacterial Infections. Biomed. Mater. 2017, 12, 045010. [Google Scholar] [CrossRef]
- Ayerbe-Algaba, R.; Gil-Marqués, M.L.; Jiménez-Mejías, M.E.; Sánchez-Encinales, V.; Parra-Millán, R.; Pachón-Ibáñez, M.E.; Pachón, E.; Smani, Y. Synergistic Activity of Niclosamide in Combination with Colistin Against Colistin-Susceptible and Colistin-Resistant Acinetobacter baumannii and Klebsiella pneumoniae. Front. Cell. Infect. Microbiol. 2018, 8, 348. [Google Scholar] [CrossRef] [Green Version]
- Milosavljevic, M.N.; Milosavljevic, J.Z.; Kocovic, A.G.; Stefanovic, S.M.; Jankovic, S.M.; Djesevic, M.; Milentijevic, M.N. Antimicrobial Treatment of Corynebacterium striatum Invasive Infections: A Systematic Review. Rev. Do Inst. De Med. Trop. De São Paulo 2021, 63, e49. [Google Scholar] [CrossRef]
- Hahn, W.O.; Werth, B.J.; Butler-Wu, S.M.; Rakita, R.M. Multidrug-Resistant Corynebacterium striatum Associated with Increased Use of Parenteral Antimicrobial Drugs. Emerg. Infect. Dis. 2016, 22, 1908–1914. [Google Scholar] [CrossRef] [Green Version]
- Savoia, D. New Antimicrobial Approaches: Reuse of Old Drugs. Curr. Drug Targets 2016, 17, 731–738. [Google Scholar] [CrossRef] [PubMed]
- Zhang, J.L.; Si, H.F.; Shang, X.F.; Zhang, X.K.; Li, B.; Zhou, X.Z.; Zhang, J.Y. New Life for an Old Drug: In Vitro and in Vivo Effects of the Anthelmintic Drug Niclosamide against Toxoplasma Gondii RH Strain. Int. J. Parasitol. Drugs Drug Resist. 2018, 9, 27–34. [Google Scholar] [CrossRef] [PubMed]
- Osada, T.; Chen, M.; Yang, X.Y.; Spasojevic, I.; Vandeusen, J.B.; Hsu, D.; Clary, B.M.; Clay, T.M.; Chen, W.; Morse, M.A.; et al. Antihelminth Compound Niclosamide Downregulates Wnt Signaling and Elicits Antitumor Responses in Tumors with Activating APC Mutations. Cancer Res. 2011, 71, 4172–4182. [Google Scholar] [CrossRef] [PubMed] [Green Version]
- Pan, J.-X.; Ding, K.; Wang, C.-Y. Niclosamide, an Old Antihelminthic Agent, Demonstrates Antitumor Activity by Blocking Multiple Signaling Pathways of Cancer Stem Cells. Chin. J. Cancer 2012, 31, 178–184. [Google Scholar] [CrossRef] [Green Version]
- Tharmalingam, N.; Port, J.; Castillo, D.; Mylonakis, E. Repurposing the Anthelmintic Drug Niclosamide to Combat Helicobacter pylori. Sci. Rep. 2018, 8, 3701. [Google Scholar] [CrossRef] [Green Version]
- Domalaon, R.; De Silva, P.M.; Kumar, A.; Zhanel, G.G.; Schweizer, F. The Anthelmintic Drug Niclosamide Synergizes with Colistin and Reverses Colistin Resistance in Gram-Negative Bacilli. Antimicrob. Agents Chemother. 2019, 63, e02574-18. [Google Scholar] [CrossRef] [Green Version]
- Sharma, A.; Gupta, V.K.; Pathania, R. Efflux Pump Inhibitors for Bacterial Pathogens: From Bench to Bedside. Indian J. Med. Res. 2019, 149, 129–145. [Google Scholar] [CrossRef]
- Guo, H.; Suzuki, T.; Rubinstein, J.L. Structure of a Bacterial ATP Synthase. eLife 2019, 8, e43128. [Google Scholar] [CrossRef]
- Copp, N.; Pletzer, D.; Brown, A.S.; Van der Heijden, J.; Miton, C.M.; Edgar, R.J.; Rich, M.H.; Little, R.F.; Williams, E.M.; Hancock, R.E.W.; et al. Mechanistic Understanding Enables the Rational Design of Salicylanilide Combination Therapies for Gram-Negative Infections. mBio 2020, 11, e02068-20. [Google Scholar] [CrossRef]
- Le, D.; Krasnopeeva, E.; Sinjab, F.; Pilizota, T.; Kim, M. Active Efflux Leads to Heterogeneous Dissipation of Proton Motive Force by Protonophores in Bacteria. mBio 2021, 12, e0067621. [Google Scholar] [CrossRef]
- Dell’Annunziata, F.; Martora, F.; Pepa, M.E.D.; Folliero, V.; Luongo, L.; Bocelli, S.; Guida, F.; Mascolo, P.; Campobasso, C.P.; Maione, S.; et al. Postmortem Interval Assessment by MALDI-TOF Mass Spectrometry Analysis in Murine Cadavers. J. Appl. Microbiol. 2022, 132, 707–714. [Google Scholar] [CrossRef] [PubMed]
- Ferraro, M.J. National Committee for Clinical Laboratory Standards. Performance Standards for Antimicrobial Disk Susceptibility Tests, 1st ed.; Clinical & Laboratory Standards Institute (CLSI): Wayne, PA, USA, 2000; pp. 1–26. [Google Scholar]
- EUCAST: Clinical Breakpoints and Dosing of Antibiotics. Available online: https://www.eucast.org/fileadmin/src/media/PDFs/EUCAST_files/Breakpoint_tables/v_12.0_Breakpoint_Tables.pdf (accessed on 1 January 2022).
- Clinical and Laboratory Standards Institute (CLSI). Available online: https://clsi.org/media/1928/m07ed11_sample.pdf (accessed on 11 January 2018).
- Franci, G.; Folliero, V.; Cammarota, M.; Zannella, C.; Sarno, F.; Schiraldi, C.; de Lera, A.R.; Altucci, L.; Galdiero, M. Epigenetic Modulator UVI5008 Inhibits MRSA by Interfering with Bacterial Gyrase. Sci. Rep. 2018, 8, 13117. [Google Scholar] [CrossRef] [PubMed]
- Morone, M.V.; Dell’Annunziata, F.; Giugliano, R.; Chianese, A.; De Filippis, A.; Rinaldi, L.; Gambardella, U.; Franci, G.; Galdiero, M.; Morone, A. Pulsed Laser Ablation of Magnetic Nanoparticles as a Novel Antibacterial Strategy against Gram-positive Bacteria. Appl. Surf. Sci. Adv. 2022, 7, 100213. [Google Scholar] [CrossRef]
- Franci, G.; Falanga, A.; Zannella, C.; Folliero, V.; Martora, F.; Galdiero, M.; Galdiero, S.; Morelli, G.; Galdiero, M. Infectivity Inhibition by Overlapping Synthetic Peptides Derived from the GH/GL Heterodimer of Herpes Simplex Virus Type 1. J. Pept. Sci. 2017, 23, 311–319. [Google Scholar] [CrossRef] [PubMed] [Green Version]

| Bacterium Characteristics | Zone Diameter Breakpoints [mm—Sensitive (S)/Resistant (R)] | ||||||||||
|---|---|---|---|---|---|---|---|---|---|---|---|
| Isolates | Biological Material of Origin | VA (5 μg) | LZD (10 μg) | CIP (5 μg) | RP (5 μg) | CD (2 μg) | PG (5 μg) | NP (5 μg) | DO (5 μg) | SE (5 μg) | MO (5 μg) |
| C. striatum S1 | Bronchial aspirate | 27 (S) | 53 (S) | 0 (R) | 0 (R) | 0 (R) | 0 (R) | 23 | ND | ND | ND |
| C. striatum S2 | Wound swab | 23 (S) | 50 (S) | 0 (R) | 0 (R) | 0 (R) | 0 (R) | 22 | ND | ND | ND |
| C. striatum S3 | Urine | 26 (S) | 55 (S) | 0 (R) | 0 (R) | 0 (R) | 0 (R) | 24 | ND | ND | ND |
| C. striatum S4 | Swab ulcer | 27 (S) | 53 (S) | 0 (R) | 0 (R) | 0 (R) | 0 (R) | 22 | ND | ND | ND |
| C. striatum S5 | Peripheral venous blood | 25 (S) | 55 (S) | 0 (R) | 0 (R) | 0 (R) | 0 (R) | 23 | ND | ND | ND |
| C. striatum S6 | Swab ulcer | 25 (S) | 55 (S) | 0 (R) | 0 (R) | 0 (R) | 0 (R) | 24 | ND | ND | ND |
| C. striatum S7 | Swab ulcer | 26 (S) | 53 (S) | 0 (R) | 0 (R) | 0 (R) | 0 (R) | 23 | ND | ND | ND |
| C. striatum S8 | Swab ulcer | 22 (S) | 56 (S) | 0 (R) | 0 (R) | 0 (R) | 0 (R) | 23 | ND | ND | ND |
| C. striatum S9 | Pus | 27 (S) | 52 (S) | 0 (R) | 0 (R) | 0 (R) | 0 (R) | 22 | ND | ND | ND |
| C. striatum S10 | Peripheral venous blood | 27 (S) | 54 (S) | 0 (R) | 0 (R) | 0 (R) | 0 (R) | 24 | ND | ND | ND |
| C. striatum S11 | Swab ulcer | 25 (S) | 56 (S) | 0 (R) | 0 (R) | 0 (R) | 0 (R) | 24 | ND | ND | ND |
| C. striatum S12 | Central venous blood catheter | 27 (S) | 56 (S) | 0 (R) | 0 (R) | 0 (R) | 0 (R) | 24 | ND | ND | ND |
| C. striatum S13 | Swab ulcer | 23 (S) | 53 (S) | 0 (R) | 0 (R) | 0 (R) | 0 (R) | 22 | ND | ND | ND |
| C. striatum S14 | Sputum | 27 (S) | 50 (S) | 0 (R) | 0 (R) | 0 (R) | 0 (R) | 23 | ND | ND | ND |
| C. striatum S15 | Swab ulcer | 26 (S) | 54 (S) | 0 (R) | 0 (R) | 0 (R) | 0 (R) | 21 | ND | ND | ND |
| C. striatum S16 | Swab ulcer | 24 (S) | 53 (S) | 0 (R) | 0 (R) | 0 (R) | 0 (R) | 23 | ND | ND | ND |
| C. striatum S17 | Throat swab | 25 (S) | 54 (S) | 0 (R) | 0 (R) | 0 (R) | 0 (R) | 23 | ND | ND | ND |
| C. striatum S18 | Bronchial aspirate | 25 (S) | 54 (S) | 0 (R) | 0 (R) | 0 (R) | 0 (R) | 24 | ND | ND | ND |
| C. striatum S19 | Urinary catheter | 27 (S) | 53 (S) | 0 (R) | 0 (R) | 0 (R) | 0 (R) | 22 | ND | ND | ND |
| C. striatum S20 | Bone biopsy | 24 (S) | 55 (S) | 0 (R) | 0 (R) | 0 (R) | 0 (R) | 23 | ND | ND | ND |
| Moxidectin | Selamectin | |
|---|---|---|
| Chemical structure |  |  |
| Molecular formula | C37H53NO8 | C43H63NO11 |
| Molecular weight | 639.82 g/mol | 769.97 g/mol |
| Appearance | white crystals | yellow crystals |
| Density | 1.2 g/cm3 | 1.35 g/cm3 |
| Melting point | 145–154 °C | N/A |
| Boiling point | 790 °C | 917.0 °C |
| Solubility in water | 0.51 mg/L | 0.43 mg/L |
| Niclosamide | Doramectin | |
| Chemical structure |  |  |
| Molecular formula | C13H8Cl2N2O4 | C50H74O14 |
| Molecular weight | 327.12 g/mol | 899.11 g/mol |
| Appearance | yellow crystals | white crystals |
| Density | 1.6 g/cm3 | 1.25 g/cm3 |
| Melting point | 225–230 °C | 116–119 °C |
| Boiling point | 424.5 °C | 967.4 °C |
| Solubility in water | 13.32 mg/L | 0.025 mg/L |
Publisher’s Note: MDPI stays neutral with regard to jurisdictional claims in published maps and institutional affiliations. |
© 2022 by the authors. Licensee MDPI, Basel, Switzerland. This article is an open access article distributed under the terms and conditions of the Creative Commons Attribution (CC BY) license (https://creativecommons.org/licenses/by/4.0/).
Share and Cite
Folliero, V.; Dell’Annunziata, F.; Roscetto, E.; Cammarota, M.; De Filippis, A.; Schiraldi, C.; Catania, M.R.; Casolaro, V.; Perrella, A.; Galdiero, M.; et al. Niclosamide as a Repurposing Drug against Corynebacterium striatum Multidrug-Resistant Infections. Antibiotics 2022, 11, 651. https://doi.org/10.3390/antibiotics11050651
Folliero V, Dell’Annunziata F, Roscetto E, Cammarota M, De Filippis A, Schiraldi C, Catania MR, Casolaro V, Perrella A, Galdiero M, et al. Niclosamide as a Repurposing Drug against Corynebacterium striatum Multidrug-Resistant Infections. Antibiotics. 2022; 11(5):651. https://doi.org/10.3390/antibiotics11050651
Chicago/Turabian StyleFolliero, Veronica, Federica Dell’Annunziata, Emanuela Roscetto, Marcella Cammarota, Anna De Filippis, Chiara Schiraldi, Maria Rosaria Catania, Vincenzo Casolaro, Alessandro Perrella, Massimiliano Galdiero, and et al. 2022. "Niclosamide as a Repurposing Drug against Corynebacterium striatum Multidrug-Resistant Infections" Antibiotics 11, no. 5: 651. https://doi.org/10.3390/antibiotics11050651
APA StyleFolliero, V., Dell’Annunziata, F., Roscetto, E., Cammarota, M., De Filippis, A., Schiraldi, C., Catania, M. R., Casolaro, V., Perrella, A., Galdiero, M., & Franci, G. (2022). Niclosamide as a Repurposing Drug against Corynebacterium striatum Multidrug-Resistant Infections. Antibiotics, 11(5), 651. https://doi.org/10.3390/antibiotics11050651














